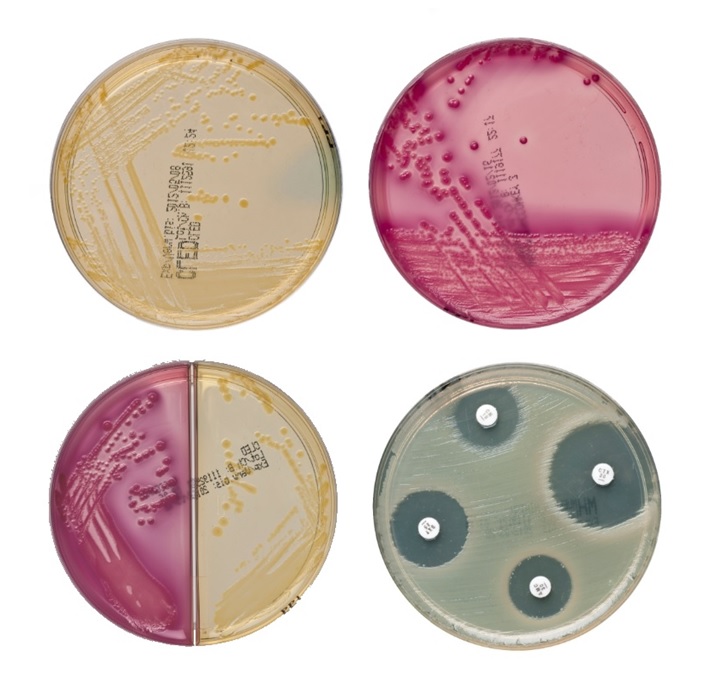

Kategorien
- Spritzen
- Kanülen
- Infusion / Transfusion
- Handschuhe
- Desinfektion / Reinigung
- Hygieneartikel / Waschraum
- Liegenabdeckung
- Wundversorgung /Verbände
- OP-Bedarf
- Chirurgische Instrumente
-
Schnellteste
- Urinteste
- Blutzuckerteste
- pH-Teste
- HCG-Schwangerschaft
- Troponin / Kardio-Teste
- Chlamydia
- Helicobacter
- Streptokokken
- CRP-Teste
- PSA-Teste
- Mononukleose-Teste
- HIV-Teste
- Drogenteste
- Photometer-Küvetten
- Gerinnungsdiagnostik
- D-Dimer
- Nährböden
- Protein-Test
- Kontrollteste
- Corona-Test
- Influenza-Test
- Krebsfrüherkennung
- Laborbedarf
- Akupunktur
- Geräte und Zubehör
- Sterilisation
- Praxiseinrichtung
- Notfall / Anästhesie
- Röntgen / MR / CT
- Urologie
Filter
Schnellteste
-
 Urinteste
Urinteste -
 Blutzuckerteste
Blutzuckerteste -
 pH-Teste
pH-Teste -
 HCG-Schwangerschaft
HCG-Schwangerschaft -
 Troponin / Kardio-Teste
Troponin / Kardio-Teste -
 Chlamydia
Chlamydia -
 Helicobacter
Helicobacter -
 Streptokokken
Streptokokken -
 CRP-Teste
CRP-Teste -
 PSA-Teste
PSA-Teste -
 Mononukleose-Teste
Mononukleose-Teste -
 HIV-Teste
HIV-Teste -
 Drogenteste
Drogenteste -
 Photometer-Küvetten
Photometer-Küvetten -
 Gerinnungsdiagnostik
Gerinnungsdiagnostik -
 D-Dimer
D-Dimer -
Nährböden
Nährböden -
 Protein-Test
Protein-Test -
 Kontrollteste
Kontrollteste -
 Corona-Test
Corona-Test -
 Influenza-Test
Influenza-Test -
 Krebsfrüherkennung
Krebsfrüherkennung
